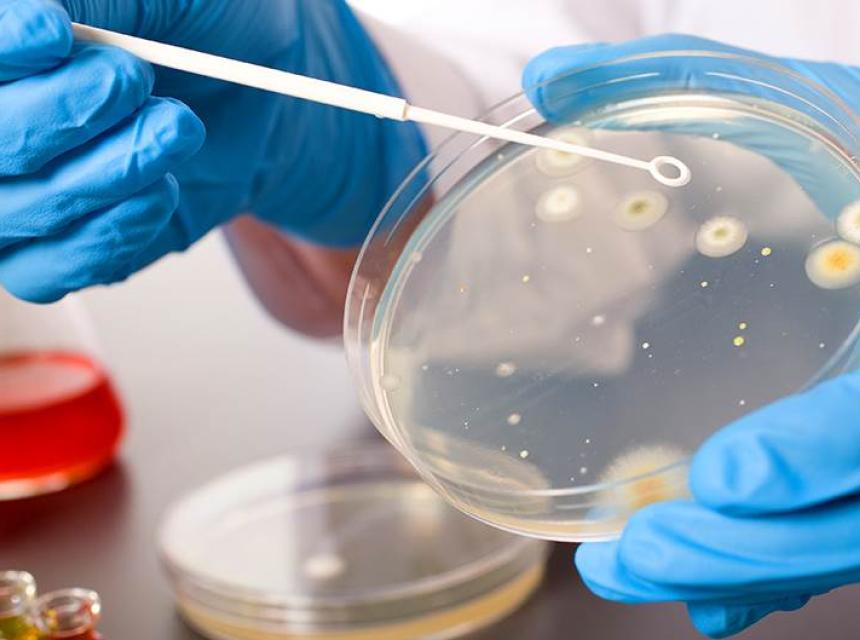

Jednoj osobi u Seattleu, koja se nedavno vratila iz Kine, dijagnosticiran je wuhanski koronavirus, izjavio je u utorak glasnogovornik američkog Centra za kontrolu bolesti i prevenciju (CDC) Benjamin Haynes.
Muškarac koji se nedavno vratio u Seattle u državi Washington iz Wuhana, gdje je bio na putu, prva je osoba zaražena novim sojem virusa, navodi CDC, prenosi N1.
Američki državljanin nije pokazivao simptome kada se vratio u zemlju prošle srijede, kada još nisu počeli pregledi putnika iz Kine u nekoliko američkih zračnih luka, prenosi dpa.
Muškarac je hospitaliziran i u dobrom je stanju te predstavlja mali rizik od zaraze za druge, rekli su dužnosnici.